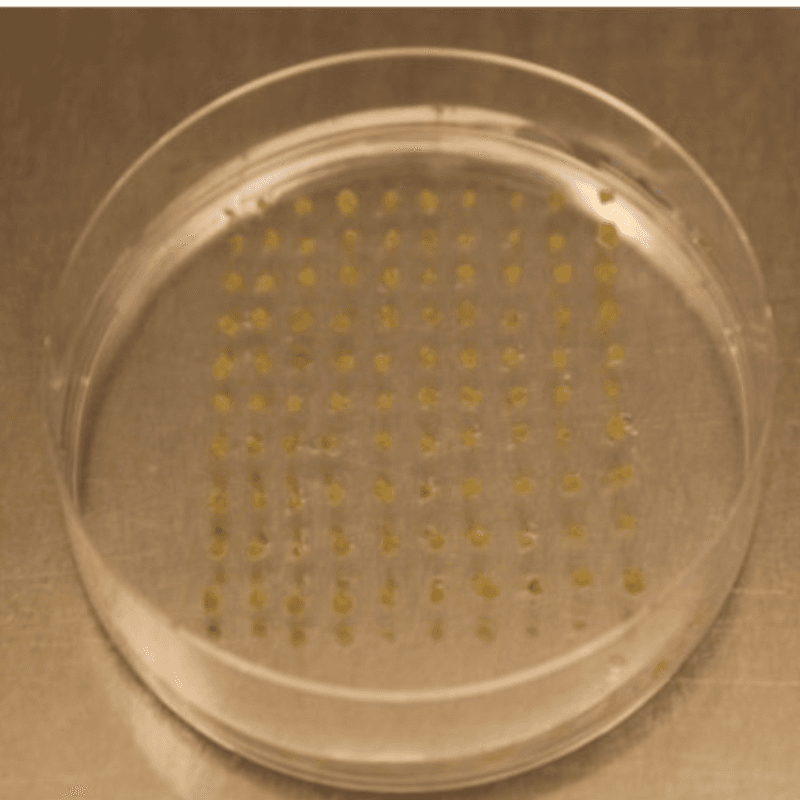
Inititiative image

El mejoramiento genético convencional siempre ha sido un proceso que requiere mucho tiempo. La reciente aparición de la Edición Génica (EG) es un salto significativo en las tecnologías de modificación genética con un alto impacto en el aumento de la buscada variabilidad. Permite realizar modificaciones de forma dirigida en la secuencia de ADN de genes específicos para alterar su expresión (silenciarlos o sobre-expresarlos), reemplazar alelos e introducir transgenes en sitios predeterminados del genoma. Puede reducir los tiempos del mejoramiento genético y producir una ventaja en la generación de animales y plantas mejoradas, por su menor costo y mayor accesibilidad. Para aprovechar plenamente esta posibilidad, es necesario generar y reforzar capacidades en EG en la región.
Hemos implementado un conjunto de soluciones tecnológicas de edición génica integradas y adaptables a especies vegetales y animales. En papa, desarrollamos y armonizamos protocolos de transformación con técnicas de edición genética CRISPR/Cas RNP y edición multiplex en eIF4E, Inv Vac y PPO— que permitieron generar líneas con resistencia viral, calidad de fritado y chip premium, con viabilidad de protoplastos de hasta 55 % y la generación de callos. En soja, estandarizamos métodos para editar simultáneamente genes clave (SBA, STS, RS), logrando variedades con mayor contenido de aminoácidos azufrados y semilla ampliada. Para ganadería, optimizamos la microinyección de RNPs en cigotos bovinos y acortamos los tiempos de fecundación a 6–8 horas para introducir la maquinaria CRISPR antes de la replicación, diseñamos guías sgRNA de alta especificidad para MSTN y BLG, y realizamos 56 transferencias embrionarias, reduciendo el mosaicismo.
Se desarrolló un protocolo de protoplastos en papa que combina extracción, transfección y regeneración mediante RNPs de CRISPR/Cas9, alcanzando hasta 55 % de viabilidad y generación de plántulas libres de ADN exógeno.
La caracterización funcional de clones editados en eIF4E, especialmente el clon Désirée, demostró resistencia eficaz al PVY, reafirmando el papel esencial de este gen en la susceptibilidad viral. Mediante edición multiplex de los genes Inv Vac y PPO se obtuvieron líneas con pardeamiento oxidativo reducido y calidad industrial premium para fritado y chip.
En soja, se armonizaron cinco métodos de transformación para editar simultáneamente SBA, STS y RS, logrando semillas de mayor tamaño y enriquecidas en aminoácidos azufrados.
Para ganadería, se diseñaron sgRNAs de alta especificidad para MSTN y BLG, se optimizó la producción in vitro acortando el tiempo de fecundación a 6–8 h e introduciendo CRISPR antes de la replicación del ADN.
Desafíos y primeros resultados de la Edición Génica